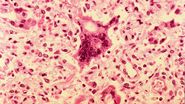

kanald.ro

Exclusiv
Cazuri alarmante de rujeolă și număr scăzut de vaccinuri! Medicii trag semnale de alarmă pentru români și vin cu sfaturi de prevenție: „A fost bomboana de pe colivă” | EXCLUSIV
Din ce în ce mai multe cazuri de rujeolă, dar din ce în ce mai puțini vaccinați. Medicii comentează situația.
Rujeola continuă să facă ravagii în țară. Tot mai multe cazuri au fost descoperite, unele dintre ele cu complicații. Trist este faptul că rata de vaccinare împotriva rujeolei a scăzut semnificativ după perioada pandemiei. Astfel, mulți nu mai cred în această metodă de prevenție. Medicul Tudor Ciuhodaru a stat de vorbă cu WOWbiz și a comentat întreaga situație.

De ce nu se mai vaccinează românii de rujeolă?
Românii nu au mai avut încredere în vaccin după pandemie, astfel că tot ce înseamnă cazuri de rujeolă și nu numai s-au înmulțit. Nu doar în țara noastră se întâmplă acest fenomen, ci și în restul Europei.
„Singurul lucru sigur în această pandemie este că încrederea în autoritățile medicale este undeva la sub nivelul mării. Au distrus tot ceea ce înseamnă informație necorespunzătoare și politizarea a foarte multe lucruri.

Rujeola, una dintre cel mai contagioase boli
Rujeola nu este o boală care să fie tratată cu indiferență. Aceasta este extrem de contagioasă și pot exista chiar complicații letale.
„Rujeola este o boală extrem de contagioasă, poți să te vaccinezi de boală și să obții imunizare, atunci este 100% și este de durată sau poți să te expui la complicații.
Ai un pont WOW? Dacă deții mai multe informații despre acest subiect ne poți scrie la adresa [email protected]!